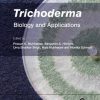

This book describes how competition between plant species, and succession in plant ecosystems, operate in grasslands and grazed pastures, both natural and sown. It discusses how competition both affects botanical structure, productivity and persistence of pastures and is itself regulated by biological, environmental and management factors, such as grazing animals. The book also examines the ways in which competition and succession are analysed, evaluated and measured, and brings to the agricultural arena the considerable progress made in understanding the principles of competition from theoretical and experimental ecology.
We ship worldwide - see checkout for options
Exceptional customer service trusted by 100's

Reviews
There are no reviews yet.